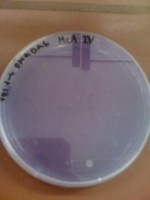

Δημιουργία και Διδακτική Αξιοποίηση Διαδραστικών Πολυμεσικών Εφαρμογών του Ψηφιακού Σχολείου
 Εισαγωγή
Η εξέλιξη της ΠΛηροφορικής και των τηλεπικοινωνιών παρέχει δυνατότητα διδακτικής αξιοποίησης πολλών εφαρμογών με τους εκπαιδευτικούς των φυσικών επιστημών να επωφελούνται [...]
Εισαγωγή
Η εξέλιξη της ΠΛηροφορικής και των τηλεπικοινωνιών παρέχει δυνατότητα διδακτικής αξιοποίησης πολλών εφαρμογών με τους εκπαιδευτικούς των φυσικών επιστημών να επωφελούνται [...]
Καρυότυπος

Στις ασκήσεις κλασικού καρυότυπου είναι πολύ συχνό το φαινόμενο να μοιράζουμε μια φωτοτυπία με [...]
ουι ουι….wikipedia

Σίγουρα θα έχετε ακούσει πολλές φορές "η wikipedia είναι ένα πολύ ωραίο εύκολο στην χρήση του [...]
Cmap tools…σίγουρο εργαλείο!

Χάρτης εννοιών ή εννοιολογικός χάρτης είναι ένα γραφικό εργαλείο πολύ χρήσιμο για [...]
Moodle…μια τάξη, πολλές δυνατότητες

Για το χτίσιμο του μαθήματος στην ηλεκτρονική τάξη επιλέχθηκε η ενότητα Αντιγραφή του DNA. Το [...]
Εικονικά περιβάλλοντα στην διδασκαλία της Βιολογίας

Βιολογία...Μια επιστήμη τόσο όμορφη όσο και πολύπλοκη. Όταν όμως έρχεται η ώρα να διδάξεις [...]
Πάμε εργαστήριο!!
Δεν μπορεί κανείς να διανοηθεί τις Φυσικές Επιστήμες χωρίς πείραμα... Η βιολογία δεν θα μπορούσε [...]
Σχετικά με τα ένζυμα…

https://www.youtube.com/watch?v=lrKgjbqZTwU
Πολλές φορές ένα καλό παράδειγμα-μια καλή αναλογία μπορεί να βοηθήσει [...]
Δυο λόγια…

Χαίρετε!
Ονομάζομαι Ευτυχία και σπούδασα Βιολογία στο αντίστοιχο τμήμα της Σχολής Θετικών [...]